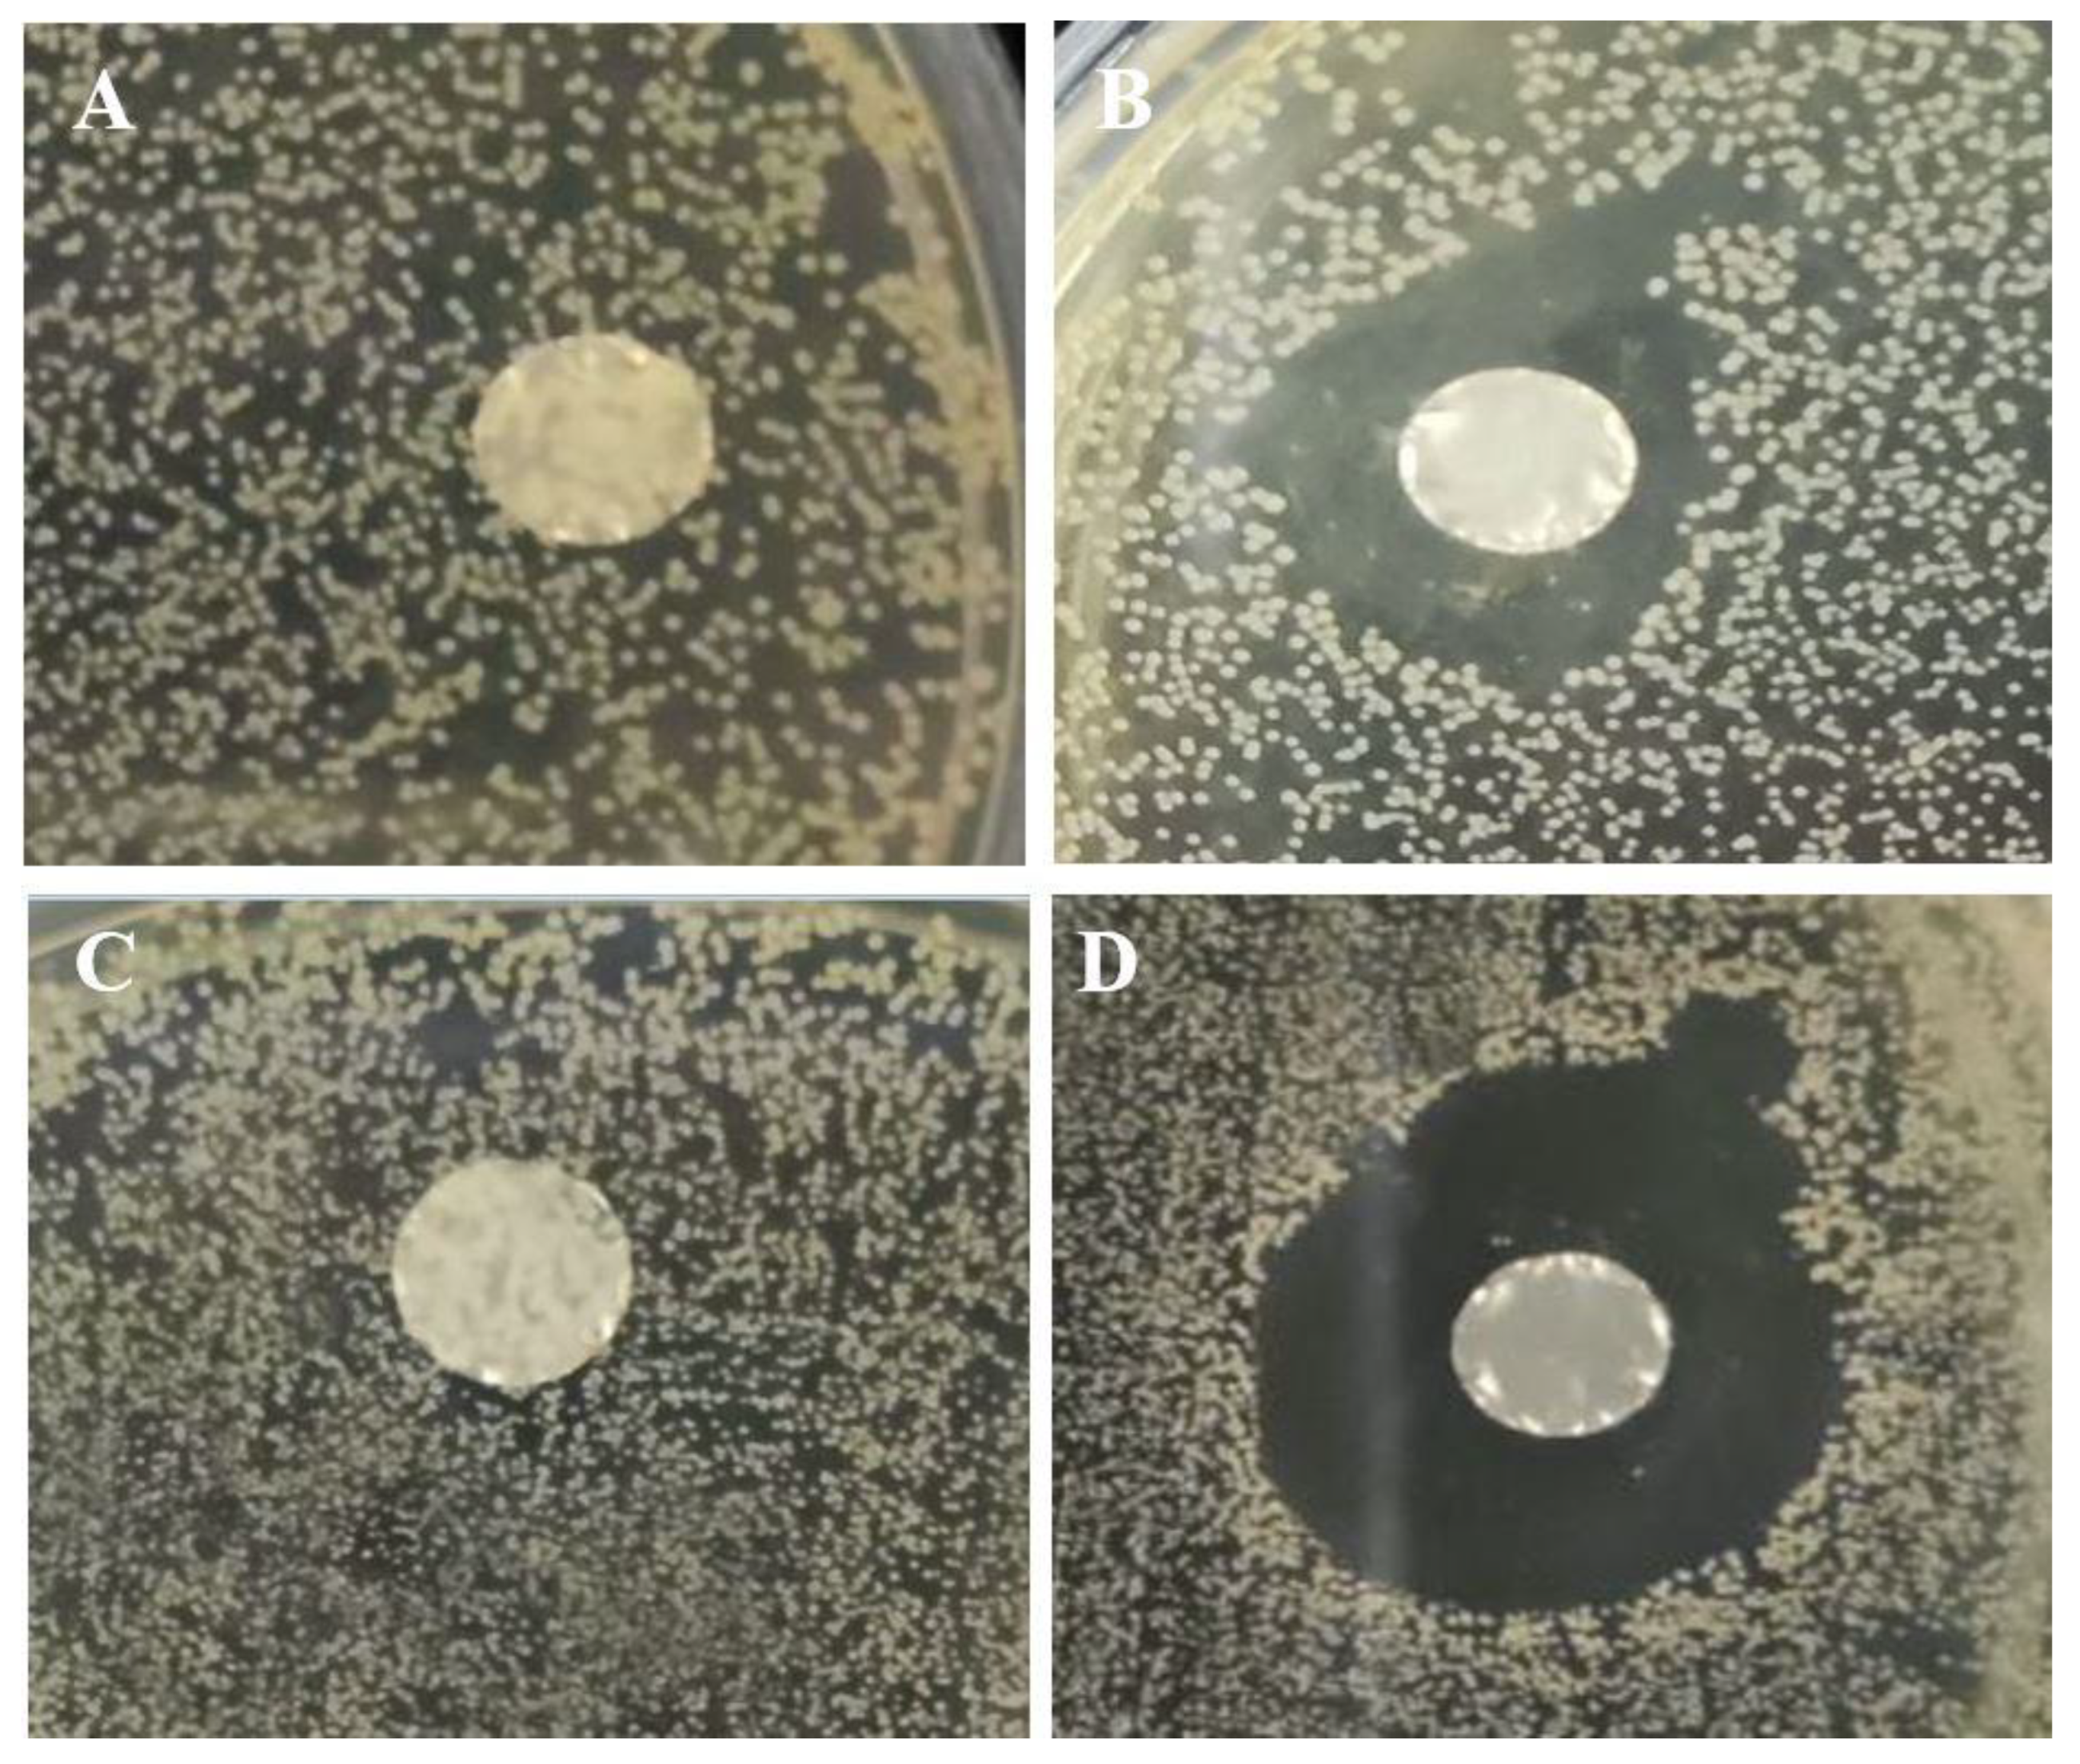
Foods 12 02588 g007 550

Fabrication of ɛ-Polylysine-Loaded Electrospun Nanofiber Mats from Persian Gum–Poly (Ethylene Oxide) and Evaluation of Their Physicochemical and Antimicrobial Properties
Abstract
:1. Introduction
2. Materials and Methods
2.1. Materials
2.2. Preparation of Spinning Solutions
2.3. Characterization of the Electrospinning Solution
2.3.1. Rheological Measurements
2.3.2. Electrical Conductivity
2.4. Electrospinning Process
2.5. Characterization of Nanofibers
2.5.1. Scanning Electron Microscopy (SEM)
2.5.2. Fourier Transforms Infrared (FT-IR)
2.5.3. X-ray Diffraction (XRD)
2.5.4. Antimicrobial Properties of Nanofibers
2.6. Statistical Analysis
3. Results and Discussion
3.1. Morphology of Nanofibers
3.2. Rheological Properties of Electrospinning Solutions
3.2.1. Steady Shear Viscosity
3.2.2. Viscoelastic Properties
3.3. Electrical Conductivity of Electrospinning Solutions
3.4. FTIR
3.5. X-ray Diffraction (XRD) of Nanofibers
3.6. Antimicrobial Activity
4. Conclusions
Author Contributions
Funding
Data Availability Statement
Conflicts of Interest
References
- Al-Tayyar, N.A.; Youssef, A.M.; Al-Hindi, R. Antimicrobial food packaging based on sustainable Bio-based materials for reducing foodborne Pathogens: A review. Food Chem. 2020, 310, 125915. [Google Scholar] [CrossRef] [PubMed]
- Hemmati, F.; Bahrami, A.; Esfanjani, A.F.; Hosseini, H.; McClements, D.J.; Williams, L. Electrospun antimicrobial materials: Advanced packaging materials for food applications. Trends Food Sci. Technol. 2021, 111, 520–533. [Google Scholar] [CrossRef]
- Hedayati, S.; Baeghbali, V.; Jafari, S.M. Application of Releasing Active Packaging in Cereals and Cereal Based Products. In Releasing Systems in Active Food Packaging: Preparation and Applications; Springer International Publishing: Cham, Switzerland, 2022; pp. 403–425. [Google Scholar]
- Akhtar, M.S.; Rafiullah, M.; Shehata, W.A.; Hossain, A.; Ali, M. Comparative phytochemical, thin layer chromatographic profiling and antioxidant activity of extracts from some Indian herbal drugs. J. Bioresour. Bioprod. 2022, 7, 128–134. [Google Scholar] [CrossRef]
- Ding, L.; Han, X.; Cao, L.; Chen, Y.; Ling, Z.; Han, J.; Jiang, S. Characterization of natural fiber from manau rattan (Calamus manan) as a potential reinforcement for polymer-based composites. J. Bioresour. Bioprod. 2022, 7, 190–200. [Google Scholar] [CrossRef]
- Liu, F.; Liu, Y.; Sun, Z.; Wang, D.; Wu, H.; Du, L.; Wang, D. Preparation and antibacterial properties of ε-polylysine-containing gelatin/chitosan nanofiber films. Int. J. Biol. Macromol. 2020, 164, 3376–3387. [Google Scholar] [CrossRef]
- Li, Y.Q.; Han, Q.; Feng, J.L.; Tian, W.L.; Mo, H.Z. Antibacterial characteristics and mechanisms of ε-poly-lysine against Escherichia coli and Staphylococcus aureus. Food Control 2014, 43, 22–27. [Google Scholar] [CrossRef]
- Shao, Z.; Yang, Y.; Fang, S.; Li, Y.; Chen, J.; Meng, Y. Mechanism of the antimicrobial activity of whey protein-ε-polylysine complexes against Escherichia coli and its application in sauced duck products. Int. J. Food Microbiol. 2020, 328, 108663. [Google Scholar] [CrossRef]
- He, S.; Liu, A.; Zhang, J.; Liu, J.; Shao, W. Preparation of ε-polylysine and hyaluronic acid self-assembled microspheres loaded bacterial cellulose aerogels with excellent antibacterial activity. Colloids Surf. A Physicochem. Eng. Asp. 2022, 654, 130114. [Google Scholar] [CrossRef]
- Rostamabadi, H.; Assadpour, E.; Tabarestani, H.S.; Falsafi, S.R.; Jafari, S.M. Electrospinning approach for nanoencapsulation of bioactive compounds; recent advances and innovations. Trends Food Sci. Technol. 2020, 100, 190–209. [Google Scholar] [CrossRef]
- Lin, L.; Mahdi, A.A.; Li, C.; Al-Ansi, W.; Al-Maqtari, Q.A.; Hashim, S.B.; Cui, H. Enhancing the properties of Litsea cubeba essential oil/peach gum/polyethylene oxide nanofibers packaging by ultrasonication. Food Packag. Shelf Life 2022, 34, 100951. [Google Scholar] [CrossRef]
- Li, C.; Bai, M.; Chen, X.; Hu, W.; Cui, H.; Lin, L. Controlled release and antibacterial activity of nanofibers loaded with basil essential oil-encapsulated cationic liposomes against Listeria monocytogenes. Food Biosci. 2022, 46, 101578. [Google Scholar] [CrossRef]
- Hadian, M.; Hosseini, S.M.H.; Farahnaky, A.; Mesbahi, G.R.; Yousefi, G.H.; Saboury, A.A. Isothermal titration calorimetric and spectroscopic studies of β-lactoglobulin-water-soluble fraction of Persian gum interaction in aqueous solution. Food Hydrocoll. 2016, 55, 108–118. [Google Scholar] [CrossRef]
- Tahsiri, Z.; Hedayati, S.; Niakousari, M. Improving the functional properties of wild almond protein isolate films by Persian gum and cold plasma treatment. Int. J. Biol. Macromol. 2023, 229, 746–751. [Google Scholar] [CrossRef] [PubMed]
- Pak, E.S.; Ghaghelestani, S.N.; Najafi, M.A. Preparation and characterization of a new edible film based on Persian gum with glycerol plasticizer. J. Food Sci. Technol. 2020, 57, 3284–3294. [Google Scholar] [CrossRef]
- Keramat, M.; Esteghlal, S.; Safari, J.; Golmakani, M.T.; Khalesi, M. Fabrication of electrospun persian gum/poly (vinyl alcohol) and whey protein isolate/poly (vinyl alcohol) nanofibers incorporated with Oliveria decumbens Vent. essential oil. Nanosci. Nanotechnol. 2019, 9, 371–380. [Google Scholar] [CrossRef]
- Li, B.; Yang, X. Rutin-loaded cellulose acetate/poly (ethylene oxide) fiber membrane fabricated by electrospinning: A bioactive material. Mater. Sci. Eng. C 2020, 109, 110601. [Google Scholar] [CrossRef]
- Yildiz, E.; Sumnu, G.; Kahyaoglu, L.N. Monitoring freshness of chicken breast by using natural halochromic curcumin loaded chitosan/PEO nanofibers as an intelligent package. Int. J. Biol. Macromol. 2021, 170, 437–446. [Google Scholar] [CrossRef]
- Colin-Orozco, J.; Zapata-Torres, M.; Rodriguez-Gattorno, G.; Pedroza-Islas, R. Properties of poly (ethylene oxide)/whey protein isolate nanofibers prepared by electrospinning. Food Biophys. 2015, 10, 134–144. [Google Scholar] [CrossRef]
- Lu, J.W.; Zhu, Y.L.; Guo, Z.X.; Hu, P.; Yu, J. Electrospinning of sodium alginate with poly (ethylene oxide). Polymer 2006, 47, 8026–8031. [Google Scholar] [CrossRef]
- Padil, V.V.T.; Senan, C.; Wacſawek, S.; Lerník, M. Electrospun fibers based on Arabic, karaya and kondagogu gums. Int. J. Biol. Macromol. 2016, 91, 299–309. [Google Scholar] [CrossRef]
- Aydogdu, A.; Sumnu, G.; Sahin, S. A novel electrospun hydroxypropyl methylcellulose/polyethylene oxide blend nanofibers: Morphology and physicochemical properties. Carbohydr. Polym. 2018, 181, 234–246. [Google Scholar] [CrossRef] [PubMed]
- Mousavi, F.; Koocheki, A.; Ghorani, B.; Mohebbi, M. Rheological properties, electrical conductivity, and surface activity of alginate/AHSG (Alyssum homolocarpum seed gum) blend and their effect on the formation of electrosprayed hydrogel beads. Rheol. Acta 2022, 61, 649–661. [Google Scholar] [CrossRef]
- Liu, J.; Cheng, D.; Zhang, D.; Han, L.; Gan, Y.; Zhang, T.; Yu, Y. Incorporating ε-polylysine hydrochloride, tea polyphenols, nisin, and ascorbic acid into edible coating solutions: Effect on quality and shelf life of marinated eggs. Food Bioprocess Technol. 2022, 15, 2683–2696. [Google Scholar] [CrossRef]
- Yu, Z.; Rao, G.; Wei, Y.; Yu, J.; Wu, S.; Fang, Y. Preparation, characterization, and antibacterial properties of biofilms comprising chitosan and ε-polylysine. Int. J. Biol. Macromol. 2019, 141, 545–552. [Google Scholar] [CrossRef] [PubMed]
- Li, T.; Wen, C.; Dong, Y.; Li, D.; Liu, M.; Wang, Z.; Song, S. Effect of ε-polylysine addition on κ-carrageenan gel properties: Rheology, water mobility, thermal stability and microstructure. Food Hydrocoll. 2019, 95, 212–218. [Google Scholar] [CrossRef]
- Moomand, K.; Lim, L.T. Effects of solvent and n-3 rich fish oil on physicochemical properties of electrospun zein fibres. Food Hydrocoll. 2015, 46, 191–200. [Google Scholar] [CrossRef]
- Mehta, P.P.; Pawar, V.S. Electrospun nanofiber scaffolds: Technology and applications. In Applications of Carbon Dots Synthesis; Sustainable Chemistry and Pharmacy; Asiri, A.M.I., Mohammad, A., Eds.; Woodhead Publishing: Sawston, UK, 2018; Volume 24, p. 100555. [Google Scholar]
- Abbasi, S. Challenges towards characterization and applications of a novel hydrocolloid: Persian gum. Curr. Opin. Colloid Interface Sci. 2017, 28, 37–45. [Google Scholar] [CrossRef]
- Allafchian, A.; Masmouei, H.R.; Jalali, S.A.H. Design and characterization of Persian gum/polyvinyl alcohol electrospun nanofibrous scaffolds for cell culture applications. Int. J. Biol. Macromol. 2022, 209, 1402–1409. [Google Scholar] [CrossRef]
- Lin, L.; Xue, L.; Duraiarasan, S.; Haiying, C. Preparation of ε-polylysine/chitosan nanofibers for food packaging against Salmonella on chicken. Food Packag. Shelf Life 2018, 17, 134–141. [Google Scholar] [CrossRef]
- Ye, R.; Xu, H.; Wan, C.; Peng, S.; Wang, L.; Xu, H.; Wei, H. Antibacterial activity and mechanism of action of ε-poly-L-lysine. Biochem. Biophys. Res. Commun. 2013, 439, 148–153. [Google Scholar] [CrossRef]

Disclaimer/Publisher’s Note: The statements, opinions and data contained in all publications are solely those of the individual author(s) and contributor(s) and not of MDPI and/or the editor(s). MDPI and/or the editor(s) disclaim responsibility for any injury to people or property resulting from any ideas, methods, instructions or products referred to in the content. |
© 2023 by the authors. Licensee MDPI, Basel, Switzerland. This article is an open access article distributed under the terms and conditions of the Creative Commons Attribution (CC BY) license (https://creativecommons.org/licenses/by/4.0/).
Share and Cite
Souri, Z.; Hedayati, S.; Niakousari, M.; Mazloomi, S.M. Fabrication of ɛ-Polylysine-Loaded Electrospun Nanofiber Mats from Persian Gum–Poly (Ethylene Oxide) and Evaluation of Their Physicochemical and Antimicrobial Properties. Foods 2023, 12, 2588. https://doi.org/10.3390/foods12132588
Souri Z, Hedayati S, Niakousari M, Mazloomi SM. Fabrication of ɛ-Polylysine-Loaded Electrospun Nanofiber Mats from Persian Gum–Poly (Ethylene Oxide) and Evaluation of Their Physicochemical and Antimicrobial Properties. Foods. 2023; 12(13):2588. https://doi.org/10.3390/foods12132588
Chicago/Turabian StyleSouri, Zahra, Sara Hedayati, Mehrdad Niakousari, and Seyed Mohammad Mazloomi. 2023. "Fabrication of ɛ-Polylysine-Loaded Electrospun Nanofiber Mats from Persian Gum–Poly (Ethylene Oxide) and Evaluation of Their Physicochemical and Antimicrobial Properties" Foods 12, no. 13: 2588. https://doi.org/10.3390/foods12132588
APA StyleSouri, Z., Hedayati, S., Niakousari, M., & Mazloomi, S. M. (2023). Fabrication of ɛ-Polylysine-Loaded Electrospun Nanofiber Mats from Persian Gum–Poly (Ethylene Oxide) and Evaluation of Their Physicochemical and Antimicrobial Properties. Foods, 12(13), 2588. https://doi.org/10.3390/foods12132588
